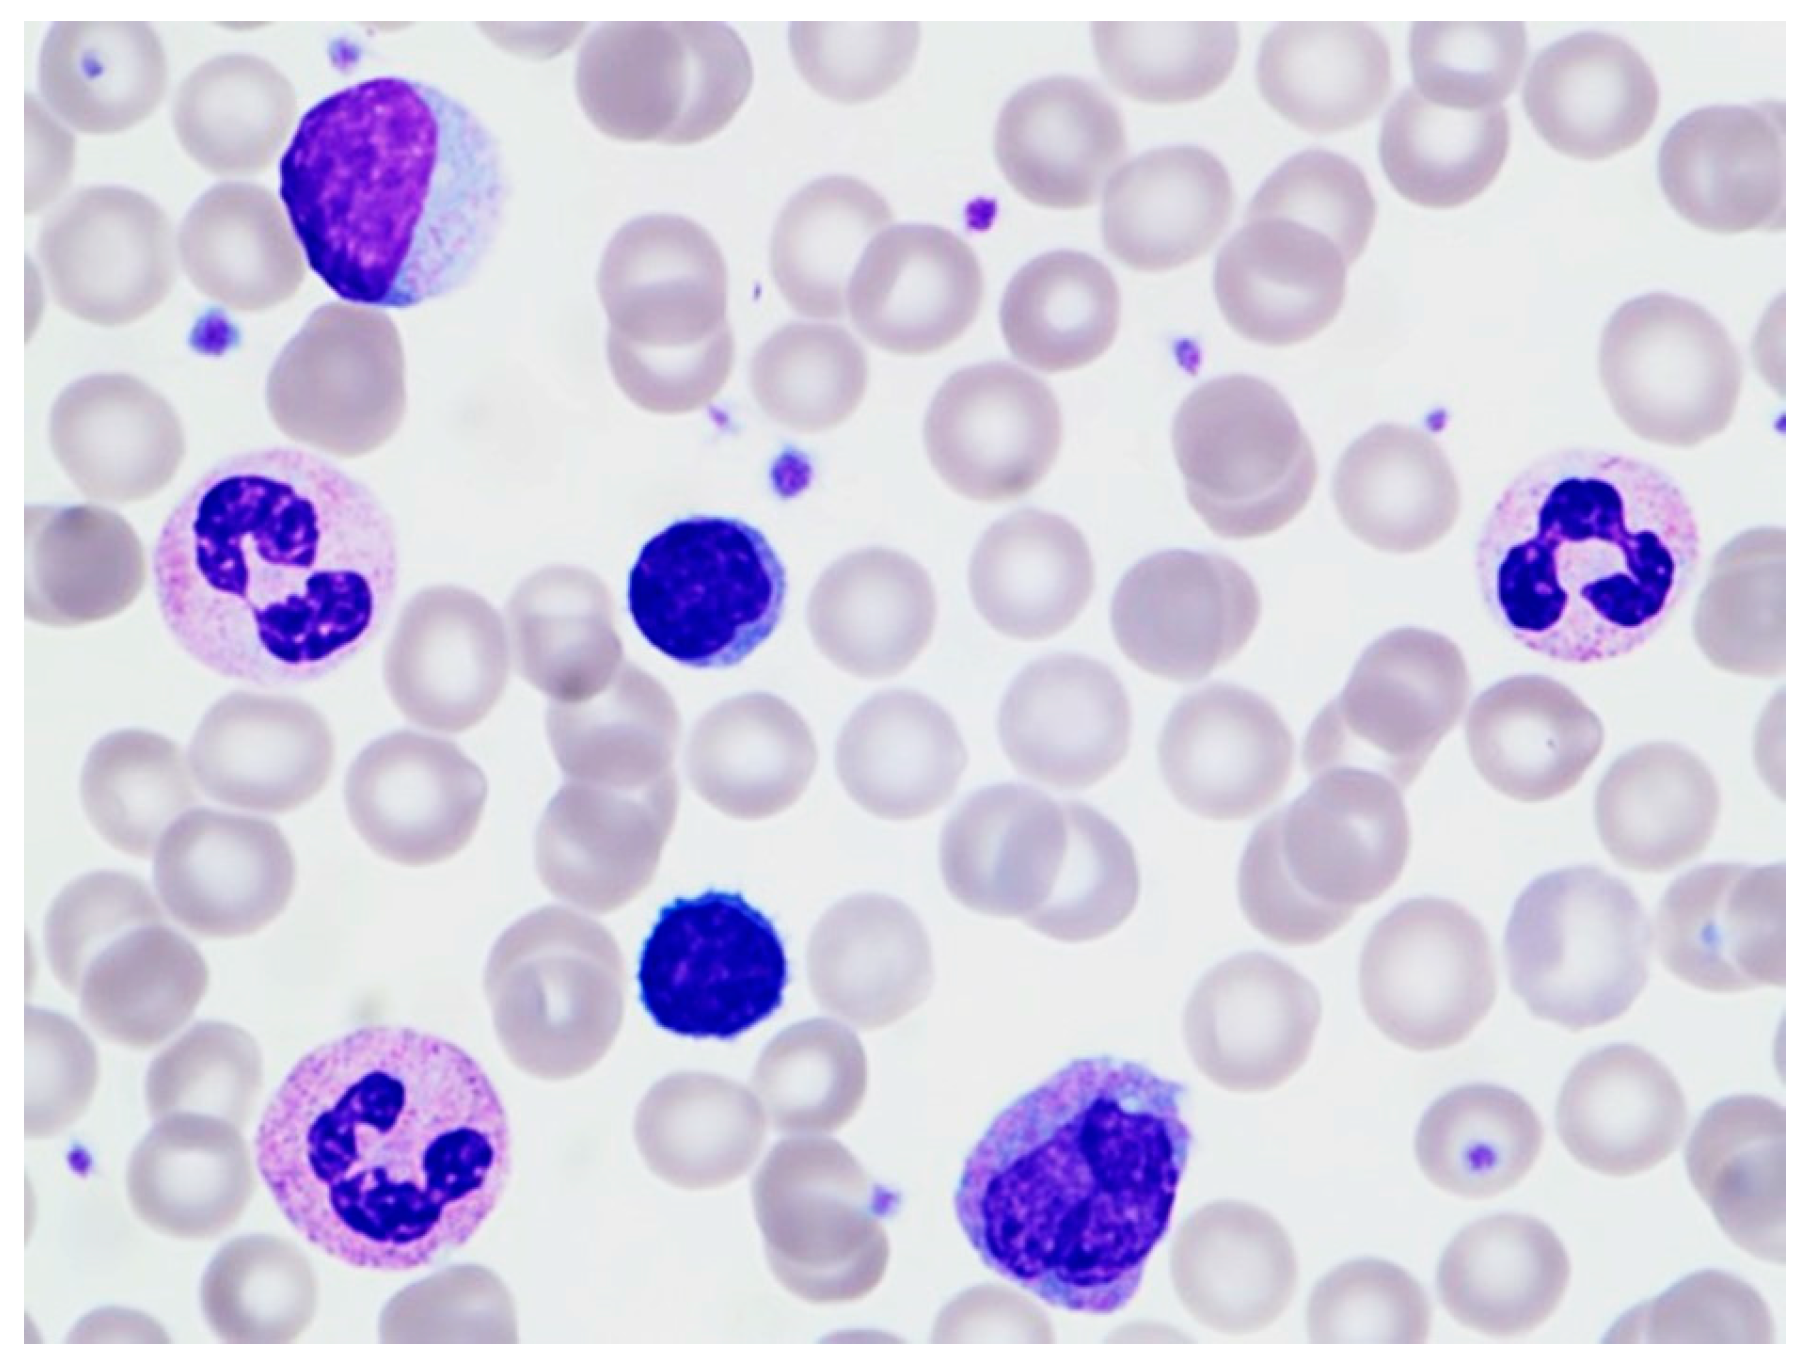
Hematolrep 16 00042 g002

Transient Stress Lymphocytosis in a Child: A Case Report and Systematic Review of the Literature
Abstract
1. Introduction
2. Case
3. Systematic Review of the Literature
4. Results
5. Discussion
Author Contributions
Funding
Institutional Review Board Statement
Informed Consent Statement
Data Availability Statement
Conflicts of Interest
References
- Ferronato, A.E.; Leite, D.; Vieira, S.E. The role of respiratory virus infection in suspected pertussis: A prospective study. J. Microbiol. Immunol. Infect. 2021, 54, 379–384. [Google Scholar] [CrossRef]
- Allen, R.; Ezekowitz, B. Hematologic manifestations of systemic diseases. In Nathan and Oski’s Hematology of Infancy and Childhood, 7th ed.; Nathan, D.G., Orkin, S.H., Eds.; Saunders: Philadelphia, PA, USA; Elsevier: Philadelphia, PA, USA, 2009; pp. 1697–1714. [Google Scholar]
- Mims, M.P. Lymphocytosis, lymphocytopenia, hypergammaglobulinemia, and hypogammaglobulinemia. In Hematology: Basic Principles and Practice, 7th ed.; Hoffman, R., Benz, E.J., Eds.; Elsevier: Philadelphia, PA, USA, 2018; pp. 682–690. [Google Scholar]
- Karandikar, N.J.; Hotchkiss, E.C.; McKenna, R.W.; Kroft, S.H. Transient stress lymphocytosis: An immunophenotypic characterization of the most common cause of newly identified adult lymphocytosis in a tertiary hospital. Am. J. Clin. Pathol. 2002, 117, 819–825. [Google Scholar] [CrossRef]
- Groom, D.A.; Kunkel, L.A.; Brynes, R.K.; Parker, J.W.; Johnson, C.S.; Endres, D. Transient stress lymphocytosis during crisis of sickle cell anemia and emergency trauma and medical conditions. An immunophenotyping study. Arch. Pathol. Lab. Med. 1990, 114, 570–576. [Google Scholar]
- Teggatz, J.R.; Parkin, J.; Peterson, L. Transient atypical lymphocytosis in patients with emergency medical conditions. Arch. Pathol. Lab. Med. 1987, 111, 712–714. [Google Scholar]
- Pinkerton, P.H.; McLellan, B.A.; Quantz, M.C.; Robinson, J.B. Acute lymphocytosis after trauma–early recognition of the high-risk patient? J. Trauma 1989, 297, 49–751. [Google Scholar] [CrossRef]
- Thommasen, H.V.; Boyko, W.J.; Montaner, J.S.; Russell, J.A.; Johnson, D.R.; Hogg, J.C. Absolute lymphocytosis associated with nonsurgical trauma. Am. J. Clin. Pathol. 1986, 86, 480–483. [Google Scholar] [CrossRef]
- Kho, H.G.; van Egmond, J.; Zhuang, C.F.; Zhang, G.L.; Lin, G.F. The patterns of stress response in patients undergoing thyroid surgery under acupuncture anaesthesia in China. Acta Anaesthesiol. Scand. 1990, 34, 563–571. [Google Scholar] [CrossRef]
- Siddiqui, M.A.; Esmaili, J.H. Transient reactive lymphocytosis-associated with acute middle cerebral artery aneurysmal rupture. J. Natl. Med. Assoc. 1997, 89, 283–284. [Google Scholar]
- Vas, M.R.; Pantalony, D.; Carstairs, K.C. Transient ‘stress lymphocytosis’. Arch. Emerg. Med. 1990, 7, 126–127. [Google Scholar] [CrossRef]
- Wentworth, P.; Salonen, V.; Pomeroy, J. Transient stress lymphocytosis during crisis of sickle cell anemia. Arch. Pathol. Lab. Med. 1991, 115, 211. [Google Scholar]
- Schatorjé, E.J.; Gemen, E.F.; Driessen, G.J.; Leuvenink, J.; van Hout, R.W.N.M.; de Vries, E. Paediatric reference values for the peripheral T cell compartment. Scand. J. Immunol. 2012, 75, 436–444. [Google Scholar] [CrossRef] [PubMed]
- Marcos-Jiménez, A.; Carvoeiro, D.C.; Ruef, N.; Cuesta-Mateos, C.; Roy-Vallejo, E.; de Soria, V.G.-G.; Laganá, C.; del Campo, L.; Zubiaur, P.; Villapalos-García, G.; et al. Dasatinib-induced spleen contraction leads to transient lymphocytosis. Blood Adv. 2023, 13, 2418–2430. [Google Scholar] [CrossRef] [PubMed]
- Sandhu, I.; Baumann, M. Transient marked increase in lymphocytosis during acute illness in chronic lymphocytic leukemia. Leuk. Res. 2011, 35, e8–e9. [Google Scholar] [CrossRef] [PubMed]
- Benschop, R.J.; Rodriguez-Feuerhahn, M.; Schedlowski, M. Catecholamine-induced leukocytosis: Early observations, current research, and future directions. Brain Behav. Immun. 1996, 10, 77–91. [Google Scholar] [CrossRef] [PubMed]
- Toft, P.; Tønnesen, E.; Svendsen, P.; Rasmussen, J.W.; Christensen, N.J. The redistribution of lymphocytes during adrenaline infusion. An in vivo study with radiolabelled cells. APMIS 1992, 100, 593–597. [Google Scholar] [CrossRef] [PubMed]
- Bromberg, L.; Roufosse, F.; Pradier, O.; Delporte, C.; Van Antwerpen, P.; De Maertelaer, V.; Cogan, E. Methylprednisolone-induced lymphocytosis in patients with immune-mediated inflammatory disorders. Am. J. Med. 2016, 129, 746–752. [Google Scholar] [CrossRef] [PubMed]
- Smith, P.R.; Cavenagh, J.D.; Milne, T.; Howe, D.; Wilkes, S.J.; Sinnott, P.; E Forster, G.; Helbert, M. Benign monoclonal expansion of CD8+ lymphocytes in HIV infection. J. Clin. Pathol. 2000, 53, 177–181. [Google Scholar] [CrossRef]
- Ehrlich, G.D.; Han, T.; Bettigole, R.; Merl, S.A.; Lehr, B.; Tomar, R.H.; Poiesz, B.J. Human T-lymphotropic virus type I-associated benign transient immature T-cell lymphocytosis. Am. J. Hematol. 1988, 27, 49–55. [Google Scholar] [CrossRef] [PubMed]
- Isobe, Y.; Hamano, Y.; Ito, Y.; Kimura, H.; Tsukada, N.; Sugimoto, K.; Komatsu, N. A monoclonal expansion of Epstein-Barr virus-infected natural killer cells after allogeneic peripheral blood stem cell transplantation. J. Clin. Virol. 2013, 56, 150–152. [Google Scholar] [CrossRef] [PubMed]
- Adachi, Y.; Morio, S.; Hirasawa, A.; Wakita, H.; Oh, H.; Yoshida, S.; Aotsuka, N.; Asai, T.; Fukazawa, T.; Itaya, T. Transient B lymphocytosis associated with hepatitis B after allogeneic bone marrow transplantation. Rinsho Ketsueki 1991, 32, 884–889. [Google Scholar]
- Ureshino, H.; Kadota, C.; Kurogi, K.; Miyahara, M.; Kimura, S. Spontaneous regression of methotrexate-related lymphoproliferative disorder with T-cell large granular lymphocytosis. Intern. Med. 2015, 54, 2235–2239. [Google Scholar] [CrossRef]
- Toyama, T. A transient lymphocytosis after administration of tirabrutinib for leukemic Waldenstrom macroglobulinemia. Rinsho Ketsueki 2023, 64, 69–72. [Google Scholar]
- Okarska-Napierała, M.; Mańdziuk, J.; Feleszko, W.; Stelmaszczyk-Emmel, A.; Panczyk, M.; Demkow, U.; Kuchar, E. Recurrent assessment of lymphocyte subsets in 32 patients with multisystem inflammatory syndrome in children (MIS-C). Pediatr. Allergy Immunol. 2021, 32, 1857–1865. [Google Scholar] [CrossRef]
- Nakahara, K.; Utsunomiya, A.; Hanada, S.; Takeshita, T.; Uozumi, K.; Yamamoto, K.; Komatsu, H.; Nitta, M.; Ueda, R.; Tatsumi, E.; et al. Transient appearance of CD3+CD8+ T lymphocytes with monoclonal gene rearrangement of T-cell receptor beta locus. Br. J. Haematol. 1998, 100, 411–414. [Google Scholar] [CrossRef]
- Scott, C.S.; Richards, S.J.; Sivakumaran, M.; Short, M.; Child, J.A.; Hunt, K.M.; McEvoy, M.; Steed, A.J.; Balfour, I.C.; Parapia, L.A.; et al. Transient and persistent expansions of large granular lymphocytes (LGL) and NK-associated (NKa) cells: The Yorkshire Leukaemia Group Study. Br. J. Haematol. 1993, 83, 505–515. [Google Scholar] [CrossRef]
- Mills, P.J.; Berry, C.C.; Dimsdale, J.E.; Ziegler, M.; Nelesen, R.; Kennedy, B. Lymphocyte subset redistribution in response to acute experimental stress: Effects of gender, ethnicity, hypertension, and the sympathetic nervous system. Brain Behav. Immun. 1995, 9, 61–69. [Google Scholar] [CrossRef]
- Chi, D.S.; Neumann, J.K.; Mota-Marquez, M.; Dubberley, F.A. Effects of acute stress on lymphocyte beta 2-adrenoceptors in white males. J. Psychosom. Res. 1993, 37, 763–770. [Google Scholar] [CrossRef]
- Iversen, P.O.; Stokland, A.; Rolstad, B.; Benestad, H.B. Adrenaline-induced leucocytosis: Recruitment of blood cells from rat spleen, bone marrow and lymphatics. Eur. J. Appl. Physiol. Occup. Physiol. 1994, 68, 219–227. [Google Scholar] [CrossRef]
- Fauci, A.S. Mechanisms of corticosteroid action on lymphocyte subpopulations. I. Redistribution of circulating T and B lymphocytes to the bone marrow. Immunology 1975, 28, 669–680. [Google Scholar]
- Gribben, J.G. Clinical manifestations, staging, and treatment of follicular lymphoma. In Hematology: Basic Principles and Practice, 7th ed.; Hoffman, R., Benz, E.J., Eds.; Elsevier: Philadelphia, PA, USA, 2018; pp. 1288–1297. [Google Scholar]
- Drews, R.E. Critical issues in hematology: Anemia, thrombocytopenia, coagulopathy, and blood product transfusions in critically ill patients. Clin. Chest Med. 2003, 24, 607–622. [Google Scholar] [CrossRef]
- Perkins, S.L.; Bradley, K.T. Lymphocytes and plasma cells. In Color Atlas of Hematology: An Illustrated Field Guide Based on Proficiency Testing, 2nd ed.; Glassy, E.F., Ed.; College of American Pathologists: Northfield, MN, USA, 2018; pp. 260–261. [Google Scholar]
- Chabot-Richards, D.S.; George, T.I. Leukocytosis. Int. J. Lab. Hematol. 2014, 36, 279–288. [Google Scholar] [CrossRef] [PubMed]
- Savaşan, S.; Al-Qanber, B.; Buck, S.; Wakeling, E.; Gadgeel, M. Clonal T-cell large granular lymphocyte proliferations in childhood and young adult immune dysregulation conditions. Pediatr. Blood Cancer 2020, 67, e28231. [Google Scholar] [CrossRef] [PubMed]

| Author (Year) | # Cases | Mean Age (Range) | Sex | ALC (× 109/L) (Mean) | Etiology | Morphology | Flow Cytometric Findings | Time to Resolution |
|---|---|---|---|---|---|---|---|---|
| Thommasen (1986) [8] | 24 | (13–65) | - | >5 | Physical trauma | Small lymphocytes | - | 6–24 h |
| Teggatz (1987) [6] | 26 | (43–93) | - | 4.1–12.9 (6.8) | Various acute medical conditions | Small lymphocytes, reactive lymphocytes, LGLs | - | 75 min (earliest) |
| Pinkerton (1989) [7] | 23 | 38 (16–78) | 17M 6F | 4.5–8.8 (5.5) | Physical trauma | - | - | |
| Groom (1990) [5] | 25 | (21–58) | 14M 11F | 5.1–11.1 | Physical trauma, Various acute medical conditions | Reactive lymphocytes, LGLs, lymphoma-like | ↑ B and T-cells ↓ CD4:CD8 | 10 to 24 h |
| Kho (1990) [9] | 17 | 38.8 | - | 4–11.5 (6.9) | Surgical removal of thyroid nodules | - | - | 48 h |
| Vas (1990) [11] | 17 | - | 5.0–13.4 (8.5) | Various acute medical conditions | Normal, lymphoma-like, or reactive lymphocytes | ↑ B-cell ↑ CD4:CD8 | 24 h | |
| Wentworth (1991) [12] | 8 | (27–66) | - | 4.2–8.5 | Physical trauma, Various acute medical conditions | - | - | Majority 24 h |
| Siddiqui (1997) [10] | 1 | 78 | F | 5.4 | Middle cerebral artery aneurysmal rupture | Reactive lymphocytes | - | 36 h |
| Karandikar (2002) [4] | 52 | 41.4 (15–89) | 22M 30F | 4–10.4 (5.1) | Physical trauma, Various acute medical conditions | Small/medium sized lymphocytes +/− Reactive/LGLs/lymphoma-like | ↑ B, T and NK-cells ↑ CD4:CD8 | 32 h Average |
Disclaimer/Publisher’s Note: The statements, opinions and data contained in all publications are solely those of the individual author(s) and contributor(s) and not of MDPI and/or the editor(s). MDPI and/or the editor(s) disclaim responsibility for any injury to people or property resulting from any ideas, methods, instructions or products referred to in the content. |
© 2024 by the authors. Licensee MDPI, Basel, Switzerland. This article is an open access article distributed under the terms and conditions of the Creative Commons Attribution (CC BY) license (https://creativecommons.org/licenses/by/4.0/).
Share and Cite
Placek, A.; Chan, R.Y.; Vergara-Lluri, M.; Brynes, R.K. Transient Stress Lymphocytosis in a Child: A Case Report and Systematic Review of the Literature. Hematol. Rep. 2024, 16, 431-439. https://doi.org/10.3390/hematolrep16030042
Placek A, Chan RY, Vergara-Lluri M, Brynes RK. Transient Stress Lymphocytosis in a Child: A Case Report and Systematic Review of the Literature. Hematology Reports. 2024; 16(3):431-439. https://doi.org/10.3390/hematolrep16030042
Chicago/Turabian StylePlacek, Alexander, Randall Y. Chan, Maria Vergara-Lluri, and Russell K. Brynes. 2024. "Transient Stress Lymphocytosis in a Child: A Case Report and Systematic Review of the Literature" Hematology Reports 16, no. 3: 431-439. https://doi.org/10.3390/hematolrep16030042
APA StylePlacek, A., Chan, R. Y., Vergara-Lluri, M., & Brynes, R. K. (2024). Transient Stress Lymphocytosis in a Child: A Case Report and Systematic Review of the Literature. Hematology Reports, 16(3), 431-439. https://doi.org/10.3390/hematolrep16030042

